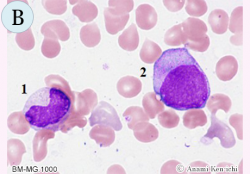

マンスリー形態マガジンの読者の皆さま、あけましておめでとうございます。新型コロナウイルスの感染拡大のなか、逼迫する医療現場で日々の業務に携わっている皆さまには心から感謝を申し上げます。
さて、昨年10月16日に公開されたアニメ映画、劇場版「鬼滅の刃~無限列車編」の興行収入が「千と千尋の神隠し」(2001)を超えて国内歴代1位を記録し、大変なブームになっています。私も遅れまいと地上波TVで初めて鑑賞しました。一部残酷なシーンもありましたが、好きなタッチで描かれておりファンになりました。物語は、時は大正の時代、主人公の竈門炭治郎(かまどたんじろう)少年は、炭を作りながら家族の暮らしを支えていました。炭次郎が留守をしたある日、家族は鬼に惨殺され、唯一生き残った妹の禰豆子(ねずこ)は鬼と化してしまいました。炭治郎は鬼を倒す鬼殺隊の道を選び、鬼を討つことで妹を人間に戻す方法を探していく、人と鬼、兄と妹が織りなる哀しくも美しくファンタジーです。
ところで、この物語のゆかりの地を調べてみますと、何と福岡県太宰府市にある宝満宮竈門(ほうまんぐうかまど)神社がファンの間で注目されているそうです。その理由として、神社名が主人公の竈門炭治郎や禰豆子(ねずこ)の苗字と同じ“竈門“であること、大宰府政庁の鬼門除けとして祀られ、鬼を敵とする「鬼滅の刃」のストーリーと通じること、また宝満宮竈門神社への修験者が着る装束が、炭治郎の羽織と同じ市松模様の柄であることなどが挙げられており、巡礼の地として多くの方が参拝されています。また、わが糸島市の神在(かみあり)神社には、炭次郎が修行の末に真っ二つに切断した一刀石に似ている巨石があり、こちらも注目を集めています。神社拝殿から参道を上ること約5分、この巨石は、神石(しんせき)として祀られ、古くから隠れパワースポットとして知られています。神石は切断されてはいませんが、空を背景に撮影すると木々の葉が一部紫色を醸し出し、不思議なパワーを感じさせます。このように九州地区には「鬼滅の刃」にまつわる聖地が多く存在しますが、これは何よりも原作者の吾峠呼世晴(ごとうげこよはる)氏が福岡県出身であることが理由かもしれません。
今回、「鬼滅の刃」のゆかりの地を訪ねてみましたが、どちらにも炭次郎や禰豆子などのイラストを描いた多くの絵馬が掛けられていました。絵馬には“コロナ撲滅”、“コロナに負けるな”といった力強いメッセージが見受けられ、私も気持ちを新たなにしました。現在、政府からは一都十府県に緊急事態宣言が発出されていますが、新型コロナの感染拡大が続いています。私もみなさんと一緒にこれまで以上“全集中”で戦いたいと思います。
「鬼滅の刃」発祥地とされる天満宮竈門神社

境内には “鬼滅”や“コロナ滅”の絵馬が
所狭しと飾られています
竈門炭治郎が切ったとされる神在神社の
神石は糸島のパワーストーンでもあります
形態マガジン号キャプテン 阿南 建一

今回の細胞編は、骨髄像における顆粒球系細胞を中心に出題しました。
顆粒球系は、細胞質の顆粒が抜けたり豊富であったり、二次的変化が多くみられますので、細胞質よりも核の所見を重視した方が同定しやすいと思われます。
症例編は、僅かな検査所見を参考にして、末梢血および骨髄の形態所見を理解して形態診断を行なって下さい。また、形態診断に不可欠な検査所見や鑑別疾患についても考えてみて下さい。
問題 1
BM-MG.1000

BM-MG.1000
BM-MG.1000

BM-MG.1000

問題 2
【60歳代.女性】 子宮がん摘出後、慢性腸閉塞にて人工肛門が装着される。その後、TPNによる高カロリー輸液や輸血を繰り返していましたが、貧血は改善されず白血球減少も来すようになりました。
WBC2,100/μL、RBC135万/μL、Hb4.8g/dL、Ht14.0%、PLT14.3万/μL
PB-MG.1000

BM-MG.400

BM-MG.1000

BM-Iron.1000

問題 1
今回は、骨髄像における鑑別細胞を提示しました。
【正答】
A-1.前骨髄球 2.前単球 3.骨髄球 4.多染性赤芽球 5.分葉核球 6.リンパ球、B-1.後骨髄球 2.前単球、
C-1.分葉核球 2.多染性赤芽球 3.分葉核球 4.前骨髄球 5.前単球 6.リンパ球、D-1.組織球 2.分葉核球
【解説】

A-1.2.細胞径18µm大、1.は細胞質の顆粒が小さいようですが、類円形核のクロマチン網工は、粗顆粒状のことから前骨髄球と思われます。2.は顆粒は小さく分散気味、核形は不整でクロマチン網工が繊細のことから前単球と思われます。3.は1.と同系で細胞は小さくなり、クロマチン網工はやや粗荒のようで骨髄球と思われます。4.は細胞質が多染性の色調、円形核のクロマチン網工は凝集状のことから多染性赤芽球と思われます。5.は3分節の分葉核球と思われます。6.は赤血球大、類円形核はクロマチン網工が粗荒のことからリンパ球と思われます。

B-1.細胞径13µm大、核幅の短径が長径の1/3以上でクロマチン網工は粗大粗荒なことから後骨髄球と思われます。桿状核球に類似していますが、クロマチン網工には結節状がみられないことをポイントにしました。2.細胞径18µm大、円形核のクロマチン網工は繊細で微細な顆粒を有することから前単球と思われます。

C-1.細胞径13µm大、核にくびれがみられ、クロマチン網工は軽度ながら結節状で、最小幅は狭小化として捉え分葉核球と思われます。2.細胞径10µm大、細胞質は多染性色調の多染性赤芽球と思われます。3.細胞径13µm大、核糸が鮮明であり、クロマチン網工は結節状であることから分葉核球と思われます。4.5.は細胞径18µm大、共に類円形核で、4.は核の偏在とクロマチン網工が繊細顆粒状のことから前骨髄球と思われます。5.は核の偏在は弱く、核形不整がみられ、クロマチン網工は繊細で少数の微細顆粒から前単球と思われます。6.細胞径10µm大、類円形核のリンパ球と思われます。

D-1.細胞径18µm大、豊富な細胞質は灰青色で空胞を有し、核は馬蹄形のようで組織球と思われます。2.細胞径13µm大、3分節の分葉核球と思われます。
問題 2
60歳代.女性、子宮がん摘出後、慢性腸閉塞を経てTPNによる高カロリー輸液や輸血を繰り返していましたが、貧血(Hb4.8g/dL)は改善されず、最近になって白血球数減少を来すようになりました。
【解説】




A.[PB-MG.1000] 大球性貧血(MCV103.7fL)、白血球数減少(2,100/µL)の血液像は好中球59%、リンパ球28%であり、赤血球形態に二相性(菲薄赤血球と正赤血球の混在)がみられました。
B.[BM-MG.400] 骨髄のNCCは16.4万/µL、MgK156/µL、M/E比は1.95で芽球は2.8%認めました。
C.[BM-MG.1000] 大型の前骨髄球や前赤芽球に明瞭な空胞、成熟赤芽球には細胞質の狭小化や不染部などの異形成を認めました。
D.[BM-Iron.1000] 骨髄の鉄染色でマクロファージに旺盛な鉄顆粒の取り込みや環状鉄芽球を55%認めました。
【他の所見】
血清鉄96µg/dL、血清フエリチン17,232µg/dL、vit.B12.1,500pg/mL、葉酸13.4ng/mL、血清銅12µg/dL、染色体:正常
【臨床診断】
末梢血の二相性赤血球、骨髄の環状鉄芽球の出現などから鉄芽球性貧血や環状鉄芽球を伴うMDSを疑いました。しかし、前者では小球性貧血のことが多いことから疑問が残ります。ただ、血清銅の低値とその後の検査でセルロプラスミンの低値が判明し、銅欠乏症が優先されました。前骨髄球の空胞化については、銅が好中球の成熟に関与しているという報告もあるようです(Halfdanarson TR, etal.2008)。環状鉄芽球やフエリチンの高値については、輸血と鉄剤投与による鉄過剰とセルロプラスミンの減少による組織からの放出障害の関与が考えられました。また二相性赤血球の出現については、銅含有酵素であるチトクロームCオキシダーゼ活性が低下したため、鉄の還元が行われず、ヘムの合成障害が起こったことが推測されました。結局、高カロリー輸液による長期中心静脈栄養(TPN)に伴う銅欠乏による貧血および白血球減少を呈したものと診断されました。TPNが長期に行われる場合は、微量元素(鉄、亜鉛、銅、セレン)などの不足につながるため、血球数を含め定期的なモニタリングが必要のようです。
【経過】
CuSO4(1.0mg/day)が投与され、開始後5日目からHbが上昇し始め、20日目で10g/dL、30日で12g/dLまで改善されました。一方、白血球数は15日目で5,000/µLまで回復しました。
これから先のページでは、医療関係者の方々を対象に医療機器・体外診断薬等の製品に関する情報を提供しております。当社製品を適正に使用していただくことを目的としており、一部の情報では専門的な用語を使用しております。
一般の方への情報提供を目的としたものではありませんので、ご了承ください。
医療関係者の方は、次のページへお進みください。
(お手数ですが、「進む」ボタンのクリックをお願いします)